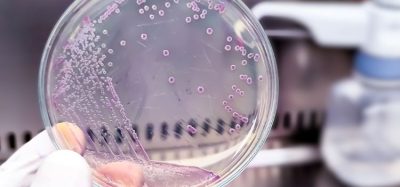
e. coli orsellinic acid

Orsellinic acid produced in E. coli for first time
By Catherine Eckford (European Pharmaceutical Review)
Sanofi’s Beyfortus shows infant benefit beyond first RSV season
By Catherine Eckford (European Pharmaceutical Review)
Fujifilm Biotechnologies inaugurates expanded £400m UK biomanufacturing site
By Catherine Eckford (European Pharmaceutical Review)
EMA opens consultation for Annex 15 GMP guidelines
By Catherine Eckford (European Pharmaceutical Review)
Accelerating consistent, stable cell line development with targeted integration
By Fei Chen (WuXi Biologics), Hang Zhou (WuXi Biologics), Tao…